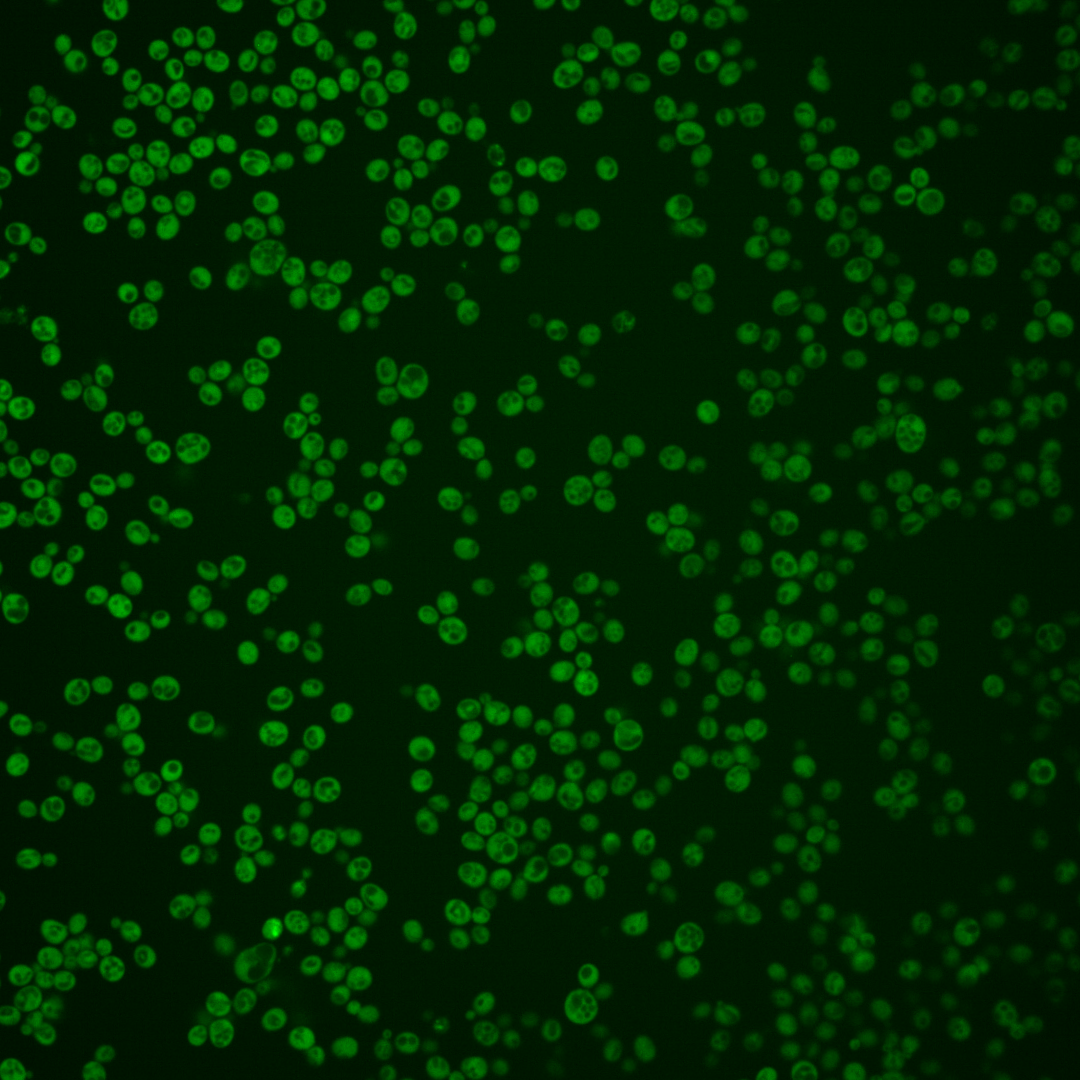
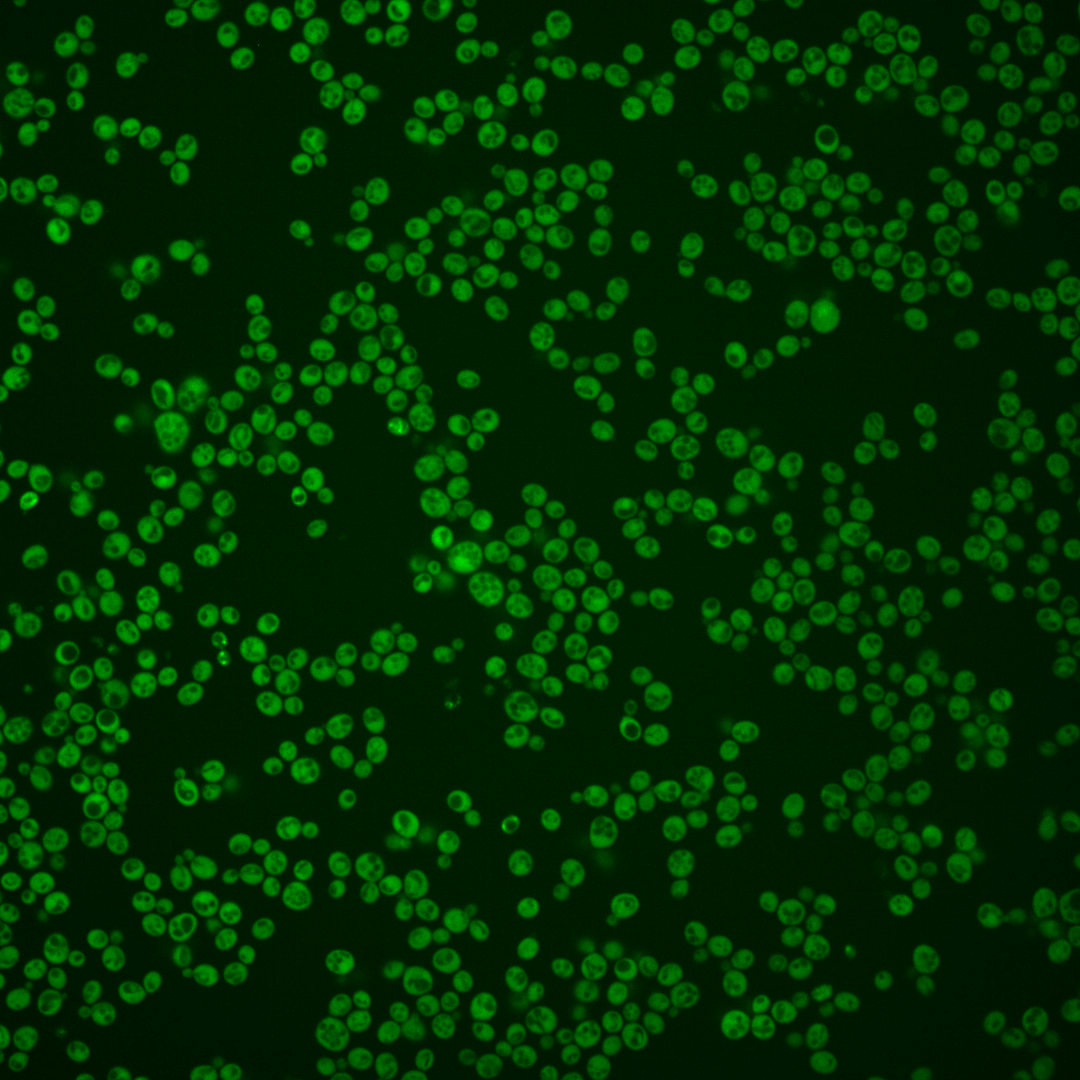
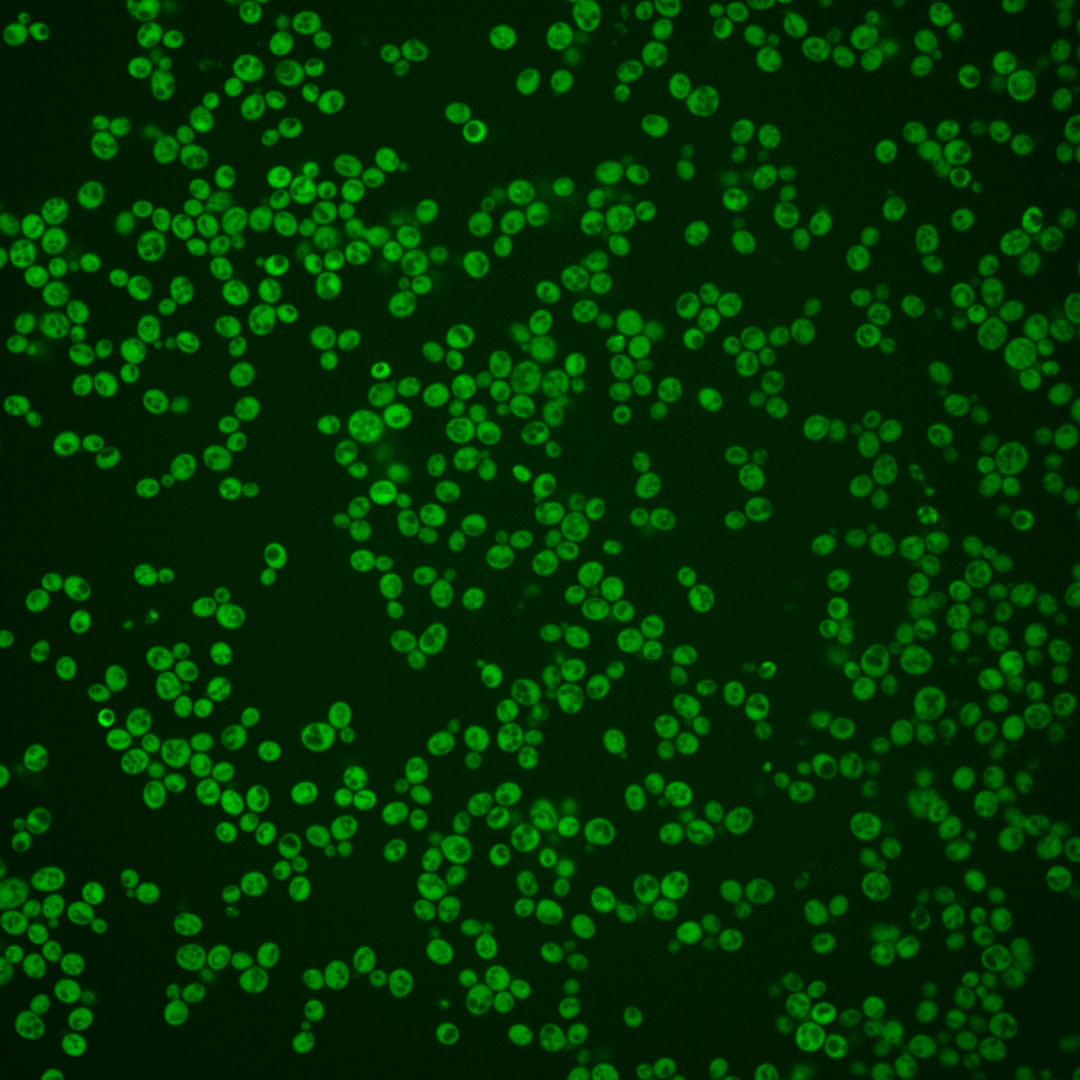
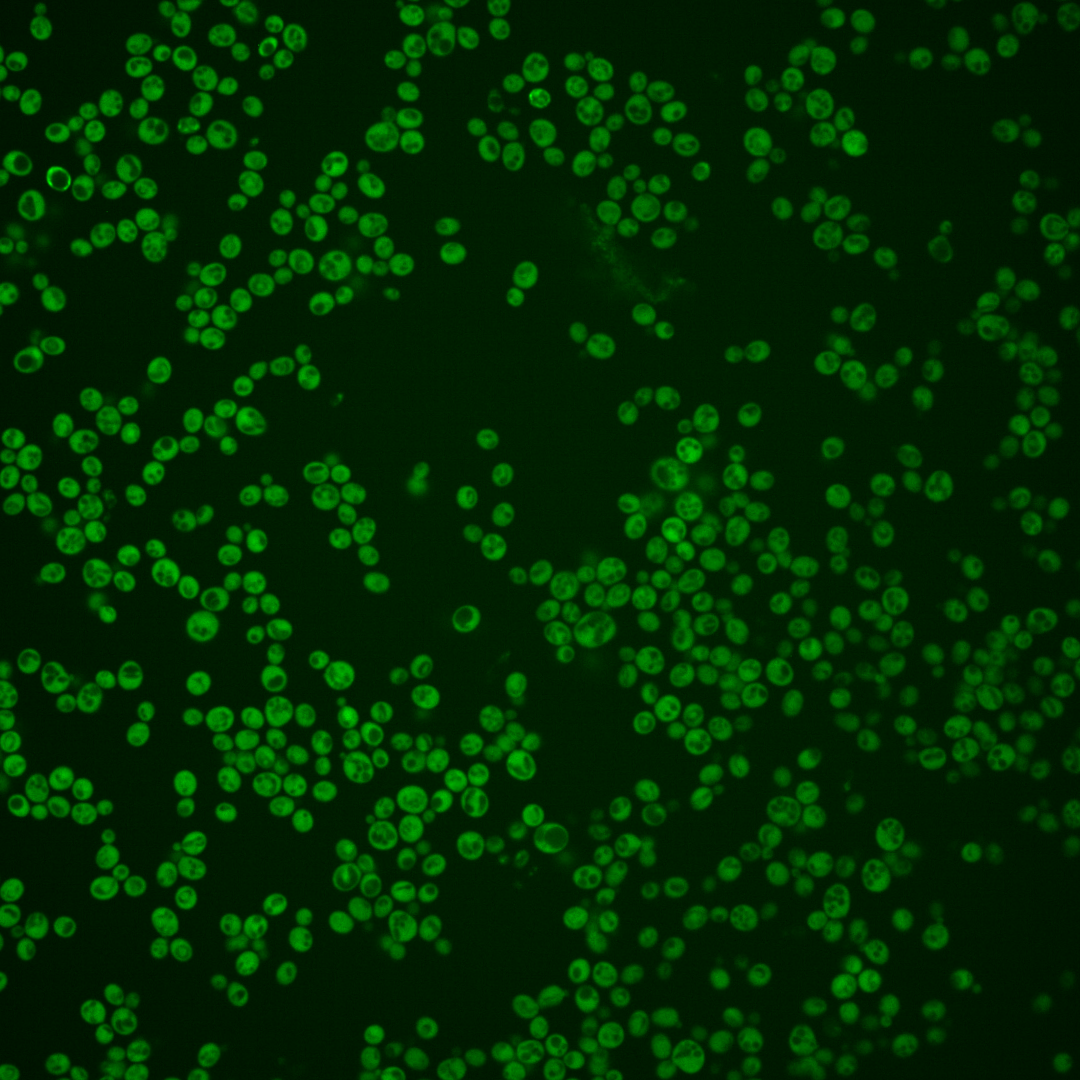

| Standard name | |
|---|---|
| Human Ortholog | |
| Description | Dual specificity protein phosphatase; regulates growth, sporulation, and glycogen accumulation in a cAMP-dependent protein kinase cascade dependent manner; mutants are defective in 60S ribosome assembly; positively regulates pre-autophagosomal structure (PAS) formation upon nitrogen starvation or rapamycin treatment |
Micrographs




















































































Sub-cellular Localization
Yeast GFP Assignment
Protein Abundance
Localization Change
External localization resources
| ensLOC | DeepLoc | |||||||||||||||||||||||
|---|---|---|---|---|---|---|---|---|---|---|---|---|---|---|---|---|---|---|---|---|---|---|---|---|
| Localization | WT1 | WT2 | WT3 | RAP60 | RAP140 | RAP220 | RAP300 | RAP380 | RAP460 | RAP540 | RAP620 | RAP700 | HU80 | HU120 | HU160 | rpd3Δ_1 | rpd3Δ_2 | rpd3Δ_3 | WT1 | WT2 | WT3 | AF100 | AF140 | AF180 |
| Cortical Patches | 0 | 0 | 0 | 0 | 0 | 1 | 1 | 0 | 1 | 1 | 1 | 0 | 0 | 0 | 0 | 0 | 0 | 0 | 1 | 0 | 0 | 1 | 0 | 1 |
| Bud | 0 | 2 | 4 | 0 | 2 | 0 | 7 | 7 | 6 | 9 | 20 | 12 | 0 | 2 | 0 | 0 | 0 | 0 | 0 | 0 | 0 | 0 | 0 | 1 |
| Bud Neck | 0 | 0 | 0 | 0 | 0 | 0 | 0 | 0 | 0 | 1 | 0 | 0 | 0 | 0 | 0 | 0 | 0 | 0 | 0 | 0 | 0 | 0 | 0 | 1 |
| Bud Site | 0 | 0 | 0 | 0 | 0 | 0 | 0 | 0 | 0 | 0 | 0 | 0 | 0 | 0 | 0 | 0 | 0 | 0 | – | – | – | – | – | – |
| Cell Periphery | 1 | 4 | 6 | 13 | 14 | 7 | 7 | 8 | 8 | 7 | 7 | 12 | 13 | 13 | 19 | 38 | 12 | 41 | 0 | 0 | 0 | 0 | 0 | 0 |
| Cytoplasm | 239 | 232 | 185 | 308 | 571 | 448 | 486 | 503 | 395 | 394 | 411 | 430 | 506 | 666 | 764 | 310 | 201 | 341 | 228 | 229 | 180 | 405 | 546 | 688 |
| Endoplasmic Reticulum | 2 | 2 | 1 | 1 | 0 | 1 | 1 | 4 | 3 | 2 | 1 | 2 | 4 | 0 | 0 | 9 | 5 | 7 | 1 | 1 | 3 | 3 | 4 | 4 |
| Endosome | 0 | 0 | 0 | 0 | 1 | 0 | 0 | 1 | 0 | 1 | 0 | 2 | 1 | 0 | 2 | 1 | 0 | 0 | 0 | 1 | 0 | 1 | 2 | 3 |
| Golgi | 0 | 0 | 0 | 0 | 1 | 0 | 2 | 0 | 0 | 0 | 0 | 0 | 0 | 1 | 1 | 1 | 0 | 1 | 1 | 0 | 0 | 0 | 0 | 0 |
| Mitochondria | 3 | 2 | 0 | 1 | 7 | 45 | 83 | 53 | 144 | 108 | 255 | 129 | 1 | 0 | 0 | 2 | 2 | 2 | 0 | 1 | 3 | 0 | 3 | 6 |
| Nucleus | 0 | 0 | 2 | 1 | 1 | 1 | 1 | 7 | 5 | 2 | 3 | 2 | 2 | 0 | 3 | 1 | 0 | 1 | 0 | 0 | 0 | 0 | 0 | 0 |
| Nuclear Periphery | 1 | 0 | 0 | 0 | 0 | 0 | 3 | 0 | 3 | 1 | 0 | 0 | 0 | 0 | 0 | 0 | 1 | 0 | 0 | 0 | 0 | 0 | 0 | 0 |
| Nucleolus | 0 | 0 | 0 | 0 | 0 | 0 | 0 | 0 | 0 | 0 | 0 | 0 | 0 | 0 | 1 | 0 | 0 | 0 | 0 | 0 | 0 | 0 | 0 | 0 |
| Peroxisomes | 0 | 0 | 0 | 0 | 0 | 0 | 0 | 0 | 0 | 0 | 0 | 0 | 0 | 0 | 1 | 0 | 0 | 0 | 0 | 0 | 0 | 0 | 0 | 0 |
| SpindlePole | 0 | 0 | 0 | 0 | 2 | 0 | 0 | 1 | 1 | 0 | 0 | 2 | 0 | 0 | 0 | 0 | 0 | 0 | 0 | 0 | 0 | 0 | 0 | 0 |
| Vac/Vac Membrane | 0 | 0 | 1 | 7 | 22 | 9 | 21 | 17 | 16 | 11 | 13 | 23 | 3 | 5 | 2 | 4 | 19 | 2 | 0 | 2 | 0 | 0 | 3 | 2 |
| Unique Cell Count | 243 | 235 | 191 | 316 | 597 | 476 | 552 | 562 | 496 | 470 | 588 | 537 | 514 | 669 | 773 | 320 | 218 | 354 | 239 | 237 | 191 | 420 | 566 | 716 |
| Labelled Cell Count | 246 | 242 | 199 | 331 | 621 | 512 | 612 | 601 | 582 | 537 | 711 | 614 | 530 | 687 | 793 | 366 | 240 | 395 | 239 | 237 | 191 | 420 | 566 | 716 |
Yeast GFP Assignment
Protein Abundance
| Screen | WT1 | WT2 | WT3 | RAP60 | RAP140 | RAP220 | RAP300 | RAP380 | RAP460 | RAP540 | RAP620 | RAP700 | HU80 | HU120 | HU160 | rpd3Δ_1 | rpd3Δ_2 | rpd3Δ_3 | AF100 | AF140 | AF180 |
|---|---|---|---|---|---|---|---|---|---|---|---|---|---|---|---|---|---|---|---|---|---|
| Mean Cell GFP Intensity (1e-4) | 7.6 | 9.8 | 8.4 | 8.7 | 7.8 | 6.0 | 5.6 | 5.8 | 4.8 | 5.2 | 4.5 | 4.9 | 9.9 | 9.8 | 9.3 | 17.9 | 17.9 | 18.3 | 9.6 | 9.2 | 9.3 |
| Std Deviation (1e-4) | 1.0 | 1.3 | 1.4 | 1.3 | 1.5 | 1.3 | 1.4 | 1.4 | 1.0 | 1.2 | 0.9 | 0.9 | 1.5 | 1.4 | 1.5 | 3.5 | 4.5 | 3.7 | 1.8 | 1.4 | 1.6 |
| Intensity Change (Log2) | – | – | – | 0.04 | -0.11 | -0.49 | -0.59 | -0.53 | -0.8 | -0.7 | -0.91 | -0.78 | 0.23 | 0.22 | 0.14 | 1.08 | 1.09 | 1.11 | 0.19 | 0.13 | 0.14 |
Localization Change
| Localization | RAP60 | RAP140 | RAP220 | RAP300 | RAP380 | RAP460 | RAP540 | RAP620 | RAP700 | HU80 | HU120 | HU160 | rpd3Δ_1 | rpd3Δ_2 | rpd3Δ_3 |
|---|---|---|---|---|---|---|---|---|---|---|---|---|---|---|---|
| Cortical Patches | 0 | 0 | 0 | 0 | 0 | 0 | 0 | 0 | 0 | 0 | 0 | 0 | 0 | 0 | 0 |
| Bud | 0 | 0 | 0 | 0 | 0 | 0 | 0 | 0 | 0 | 0 | 0 | 0 | 0 | 0 | 0 |
| Bud Neck | 0 | 0 | 0 | 0 | 0 | 0 | 0 | 0 | 0 | 0 | 0 | 0 | 0 | 0 | 0 |
| Bud Site | 0 | 0 | 0 | 0 | 0 | 0 | 0 | 0 | 0 | 0 | 0 | 0 | 0 | 0 | 0 |
| Cell Periphery | 0.6 | 0 | 0 | 0 | 0 | 0 | 0 | 0 | 0 | -0.4 | 0 | 0 | 3.4 | 1.2 | 3.3 |
| Cytoplasm | 0.4 | -0.7 | -1.5 | -3.5 | -3.1 | -5.6 | -4.6 | -7.6 | -5.5 | 1.3 | 3.2 | 2.0 | 0 | -2.0 | -0.3 |
| Endoplasmic Reticulum | 0 | 0 | 0 | 0 | 0 | 0 | 0 | 0 | 0 | 0 | 0 | 0 | 0 | 0 | 0 |
| Endosome | 0 | 0 | 0 | 0 | 0 | 0 | 0 | 0 | 0 | 0 | 0 | 0 | 0 | 0 | 0 |
| Golgi | 0 | 0 | 0 | 0 | 0 | 0 | 0 | 0 | 0 | 0 | 0 | 0 | 0 | 0 | 0 |
| Mitochondria | 0 | 0 | 4.4 | 5.7 | 4.4 | 0 | 7.2 | 0 | 7.5 | 0 | 0 | 0 | 0 | 0 | 0 |
| Nucleus | 0 | 0 | 0 | 0 | 0 | 0 | 0 | 0 | 0 | 0 | 0 | 0 | 0 | 0 | 0 |
| Nuclear Periphery | 0 | 0 | 0 | 0 | 0 | 0 | 0 | 0 | 0 | 0 | 0 | 0 | 0 | 0 | 0 |
| Nucleolus | 0 | 0 | 0 | 0 | 0 | 0 | 0 | 0 | 0 | 0 | 0 | 0 | 0 | 0 | 0 |
| Peroxisomes | 0 | 0 | 0 | 0 | 0 | 0 | 0 | 0 | 0 | 0 | 0 | 0 | 0 | 0 | 0 |
| SpindlePole | 0 | 0 | 0 | 0 | 0 | 0 | 0 | 0 | 0 | 0 | 0 | 0 | 0 | 0 | 0 |
| Vacuole | 0 | 2.3 | 0 | 2.3 | 0 | 0 | 0 | 0 | 2.5 | 0 | 0 | 0 | 0 | 3.8 | 0 |
External localization resources
Images






























Protein Concentration and Protein Localization Data
| R1 | R2 | R3 | ||||||||||||||||
|---|---|---|---|---|---|---|---|---|---|---|---|---|---|---|---|---|---|---|
| G1 Pre-START | G1 Post-START | S/G2 | Metaphase | Anaphase | Telophase | G1 Pre-START | G1 Post-START | S/G2 | Metaphase | Anaphase | Telophase | G1 Pre-START | G1 Post-START | S/G2 | Metaphase | Anaphase | Telophase | |
| Concentration | 5.1856 | 6.6392 | 5.9159 | 5.6195 | 5.1158 | 5.7828 | 4.0107 | 6.0209 | 4.7799 | 4.1965 | 4.0891 | 4.849 | 4.1713 | 5.5595 | 4.7463 | 4.4523 | 4.4313 | 4.5942 |
| Actin | 0.0188 | 0.0007 | 0.0072 | 0.0035 | 0.0049 | 0.0014 | 0.022 | 0.0005 | 0.0123 | 0.009 | 0.0056 | 0.0054 | 0.0002 | 0.0001 | 0.0003 | 0 | 0.0001 | 0.0001 |
| Bud | 0.0021 | 0.0017 | 0.0041 | 0.0005 | 0.0006 | 0.0004 | 0.0002 | 0.0001 | 0.004 | 0.0004 | 0.0003 | 0.0001 | 0.0001 | 0.0001 | 0.0002 | 0.0001 | 0.0001 | 0.0001 |
| Bud Neck | 0.007 | 0.0002 | 0.0041 | 0.0004 | 0.0009 | 0.001 | 0.0015 | 0.0001 | 0.0021 | 0.0005 | 0.0009 | 0.0006 | 0.0001 | 0.0001 | 0.0002 | 0.0002 | 0.0003 | 0.0004 |
| Bud Periphery | 0.0018 | 0.0006 | 0.0019 | 0.0003 | 0.0008 | 0.0007 | 0.0002 | 0 | 0.0017 | 0.0002 | 0.0003 | 0.0001 | 0 | 0 | 0 | 0 | 0 | 0 |
| Bud Site | 0.0064 | 0.0041 | 0.0092 | 0.001 | 0.0009 | 0.0002 | 0.0015 | 0.0004 | 0.006 | 0.0003 | 0.0004 | 0.0001 | 0.0002 | 0.0003 | 0.0002 | 0.0001 | 0.0001 | 0.0001 |
| Cell Periphery | 0.0003 | 0.0001 | 0.0007 | 0 | 0.0002 | 0.0003 | 0.0002 | 0 | 0.0003 | 0.0001 | 0.0001 | 0 | 0.0001 | 0 | 0 | 0 | 0 | 0 |
| Cytoplasm | 0.8043 | 0.9553 | 0.8936 | 0.8924 | 0.7712 | 0.9081 | 0.8377 | 0.9727 | 0.8934 | 0.8865 | 0.8387 | 0.9347 | 0.9587 | 0.9749 | 0.9753 | 0.9636 | 0.9617 | 0.9625 |
| Cytoplasmic Foci | 0.0276 | 0.0087 | 0.0155 | 0.0219 | 0.0345 | 0.018 | 0.0247 | 0.0054 | 0.0127 | 0.0136 | 0.0147 | 0.0122 | 0.0065 | 0.0072 | 0.0065 | 0.0094 | 0.0113 | 0.0096 |
| Eisosomes | 0.0002 | 0 | 0.0002 | 0 | 0.0001 | 0 | 0.0003 | 0 | 0.0002 | 0.0008 | 0.0003 | 0 | 0 | 0 | 0 | 0 | 0 | 0 |
| Endoplasmic Reticulum | 0.0091 | 0.001 | 0.0022 | 0.0029 | 0.0046 | 0.0031 | 0.0153 | 0.0022 | 0.004 | 0.0026 | 0.0048 | 0.005 | 0.009 | 0.0017 | 0.0025 | 0.0027 | 0.0018 | 0.004 |
| Endosome | 0.0303 | 0.0046 | 0.0159 | 0.01 | 0.05 | 0.0197 | 0.0252 | 0.0047 | 0.015 | 0.0214 | 0.0372 | 0.0208 | 0.0109 | 0.0082 | 0.0063 | 0.0154 | 0.0181 | 0.0146 |
| Golgi | 0.0094 | 0.0005 | 0.0037 | 0.002 | 0.017 | 0.0063 | 0.0053 | 0.0006 | 0.0049 | 0.0028 | 0.0065 | 0.0027 | 0.0011 | 0.0005 | 0.0022 | 0.0002 | 0.0004 | 0.001 |
| Lipid Particles | 0.0032 | 0.0001 | 0.0025 | 0.0003 | 0.0055 | 0.0036 | 0.0078 | 0 | 0.0078 | 0.0157 | 0.0138 | 0.0033 | 0.0002 | 0 | 0.0001 | 0 | 0 | 0 |
| Mitochondria | 0.0071 | 0.0003 | 0.0033 | 0.001 | 0.0429 | 0.0056 | 0.0058 | 0.0002 | 0.0085 | 0.0009 | 0.0334 | 0.001 | 0.0003 | 0.0002 | 0.0005 | 0.0002 | 0.0002 | 0.0007 |
| None | 0.048 | 0.0179 | 0.0201 | 0.0527 | 0.0175 | 0.0229 | 0.0323 | 0.0109 | 0.0103 | 0.0218 | 0.0217 | 0.006 | 0.0082 | 0.0038 | 0.0027 | 0.0026 | 0.0021 | 0.003 |
| Nuclear Periphery | 0.0034 | 0.0004 | 0.001 | 0.0009 | 0.0085 | 0.0006 | 0.0028 | 0.0003 | 0.0012 | 0.0016 | 0.0063 | 0.0023 | 0.0009 | 0.0003 | 0.0004 | 0.0006 | 0.0004 | 0.0005 |
| Nucleolus | 0.0005 | 0 | 0.0005 | 0.0001 | 0.0006 | 0.0001 | 0.0002 | 0 | 0.0037 | 0.0003 | 0.0008 | 0 | 0 | 0 | 0 | 0 | 0 | 0 |
| Nucleus | 0.0034 | 0.0014 | 0.0027 | 0.0022 | 0.0255 | 0.0012 | 0.0012 | 0.0006 | 0.0014 | 0.0013 | 0.0047 | 0.0008 | 0.0009 | 0.0007 | 0.0009 | 0.0011 | 0.0009 | 0.0011 |
| Peroxisomes | 0.0078 | 0.0003 | 0.0071 | 0.0036 | 0.0063 | 0.0037 | 0.0098 | 0 | 0.0064 | 0.0096 | 0.002 | 0.0019 | 0 | 0 | 0.0002 | 0 | 0.0001 | 0 |
| Punctate Nuclear | 0.003 | 0.0003 | 0.0011 | 0.0013 | 0.0023 | 0.0011 | 0.0029 | 0.0001 | 0.0011 | 0.003 | 0.0033 | 0.0013 | 0.0001 | 0.0001 | 0.0001 | 0.0001 | 0.0001 | 0.0001 |
| Vacuole | 0.0044 | 0.0015 | 0.0026 | 0.0024 | 0.0032 | 0.0014 | 0.0024 | 0.001 | 0.0025 | 0.0064 | 0.0028 | 0.0011 | 0.002 | 0.0013 | 0.0011 | 0.003 | 0.0017 | 0.0015 |
| Vacuole Periphery | 0.0017 | 0.0002 | 0.0005 | 0.0005 | 0.0019 | 0.0005 | 0.0007 | 0.0002 | 0.0006 | 0.0014 | 0.0015 | 0.0006 | 0.0003 | 0.0003 | 0.0003 | 0.0007 | 0.0005 | 0.0006 |
Sequencing Data
| R1 | R2 | |||||||||
|---|---|---|---|---|---|---|---|---|---|---|
| G1 Post-START | S/G2 | Metaphase | Anaphase | Telophase | G1 Post-START | S/G2 | Metaphase | Anaphase | Telophase | |
| Gene Expression | 39.2993 | 45.04 | 44.785 | 27.3855 | 32.6624 | 38.2705 | 36.8873 | 22.4375 | 22.9431 | 32.3581 |
| Translational Efficiency | 1.3609 | 1.3863 | 0.9284 | 1.1992 | 1.153 | 0.8746 | 1.117 | 1.207 | 1.0119 | 1.1218 |
Hit Data
| Dataset | Hit |
|---|---|
| Protein Concentration | ✘ |
| Protein Localization | ✘ |
| Gene Expression | ✘ |
| Translational Efficiency | ✘ |
Endocytosis
| Temp | Actin Patch (Sac6-tdTomato) | Cortical Patch (Sla1-GFP) | Late Endosome (Snf7-GFP) | Vacuole (Vph1-GFP) |
|---|---|---|---|---|
| 37℃ | ||||
| RT |
Cell Cycle Omics
CYCLoPs (Yvh1-GFP)
| Gene / Allele | Actin Patch (Sac6-tdTomato) | Cortical Patch (Sla1-GFP) | Late Endosome (Snf7-GFP) | Vacuole (Sac6-tdTomato) |
|---|
| Gene | Images |
|---|
| Gene | Images |
|---|
Images are not yet available
Images are not yet available